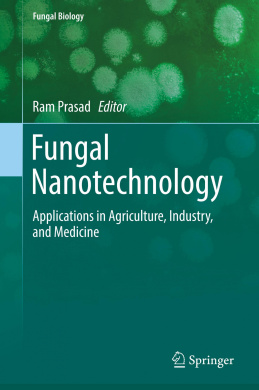
https://atpr.org/sb2/uoYBr0Enn3l620Z7yH.jpeg

-
-75%
$56.00 Original price was: $56.00.$14.00Current price is: $14.00.
-
-92%
$87.00 Original price was: $87.00.$7.00Current price is: $7.00.
-
-83%
$103.00 Original price was: $103.00.$18.00Current price is: $18.00.
-
-69%
$55.00 Original price was: $55.00.$17.00Current price is: $17.00.
-
-74%
$42.00 Original price was: $42.00.$11.00Current price is: $11.00.
-
-65%
$40.00 Original price was: $40.00.$14.00Current price is: $14.00.
-
-82%
$85.00 Original price was: $85.00.$15.00Current price is: $15.00.
-
-87%
$82.00 Original price was: $82.00.$11.00Current price is: $11.00.
-
-85%
$113.00 Original price was: $113.00.$17.00Current price is: $17.00.
-
-85%
$74.00 Original price was: $74.00.$11.00Current price is: $11.00.
-
-85%
$98.00 Original price was: $98.00.$15.00Current price is: $15.00.
-
-89%
$62.00 Original price was: $62.00.$7.00Current price is: $7.00.